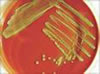

| İnkubasyon |

İnkubasyon |

İnkubasyon |
| Gelişme sağlama işlemi Mikroorganizmaların belirli sıcaklıkta tutularak gelişmesini sağlama işlemi. Tavukçuluktaki "kuluçka" ile aynı amaca yöneliktir. |
| İnkubasyon |

İnkubasyon |
İnkubasyon |
| Gelişme sağlama işlemi Mikroorganizmaların belirli sıcaklıkta tutularak gelişmesini sağlama işlemi. Tavukçuluktaki "kuluçka" ile aynı amaca yöneliktir. |